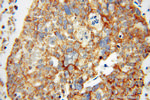
MRPL44 Antibody in Immunohistochemistry (Paraffin) (IHC (P))

Search
Proteintech
MRPL44 Polyclonal Antibody
{{$productOrderCtrl.translations['antibody.pdp.commerceCard.promotion.promotions']}}
{{$productOrderCtrl.translations['antibody.pdp.commerceCard.promotion.viewpromo']}}
{{$productOrderCtrl.translations['antibody.pdp.commerceCard.promotion.promocode']}}: {{promo.promoCode}} {{promo.promoTitle}} {{promo.promoDescription}}. {{$productOrderCtrl.translations['antibody.pdp.commerceCard.promotion.learnmore']}}
产品信息
16394-1-AP
种属反应
已发表种属
宿主/亚型
分类
类型
抗原
偶联物
形式
浓度
规格
纯化类型
保存液
内含物
保存条件
运输条件
产品详细信息
Immunogen sequence: MASGLVRLL QQGHRCLLAP VAPKLVPPVR GVKKGFRAAF RFQKELERQR LLRCPPPPVR RSEKPNWDYH AEIQAFGHRL QENFSLDLLK TAFVNSCYIK SEEAKRQQLG IEKEAVLLNL KSNQELSEQG TSFSQTCLTQ FLEDEYPDMP TEGIKNLVDF LTGEEVVCHV ARNLAVEQLT LSEEFPVPPA VLQQTFFAVI GALLQSSGPE RTALFIRDFL ITQMTGKELF EMWKIINPMG LLVEELKKRN VSAPESRLTR QSGGTTALPL YFVGLYCDKK LIAEGPGETV LVAEEE (1-295 aa encoded by B C012058)
靶标信息
Mammalian mitochondrial ribosomal proteins are encoded by nuclear genes and help in protein synthesis within the mitochondrion. Mitochondrial ribosomes (mitoribosomes) consist of a small 28S subunit and a large 39S subunit. They have an estimated 75% protein to rRNA composition compared to prokaryotic ribosomes, where this ratio is reversed. Another difference between mammalian mitoribosomes and prokaryotic ribosomes is that the latter contain a 5S rRNA. Among different species, the proteins comprising the mitoribosome differ greatly in sequence, and sometimes in biochemical properties, which prevents easy recognition by sequence homology. This gene encodes a 39S subunit protein.
仅用于科研。不用于诊断过程。未经明确授权不得转售。
生物信息学
蛋白别名: 39S ribosomal protein L44, mitochondrial; l44; L44mt; Large ribosomal subunit protein mL44; mitochondrial large ribosomal subunit protein mL44; MRP-L44; MRPL44; RM44; unnamed protein product
基因别名: 1810030E18Rik; 5730593H20Rik; AI463302; COXPD16; L44MT; mL44; MRP-L44; MRPL44
UniProt ID: (Human) Q9H9J2, (Mouse) Q9CY73
Entrez Gene ID: (Human) 65080, (Mouse) 69163, (Rat) 301552